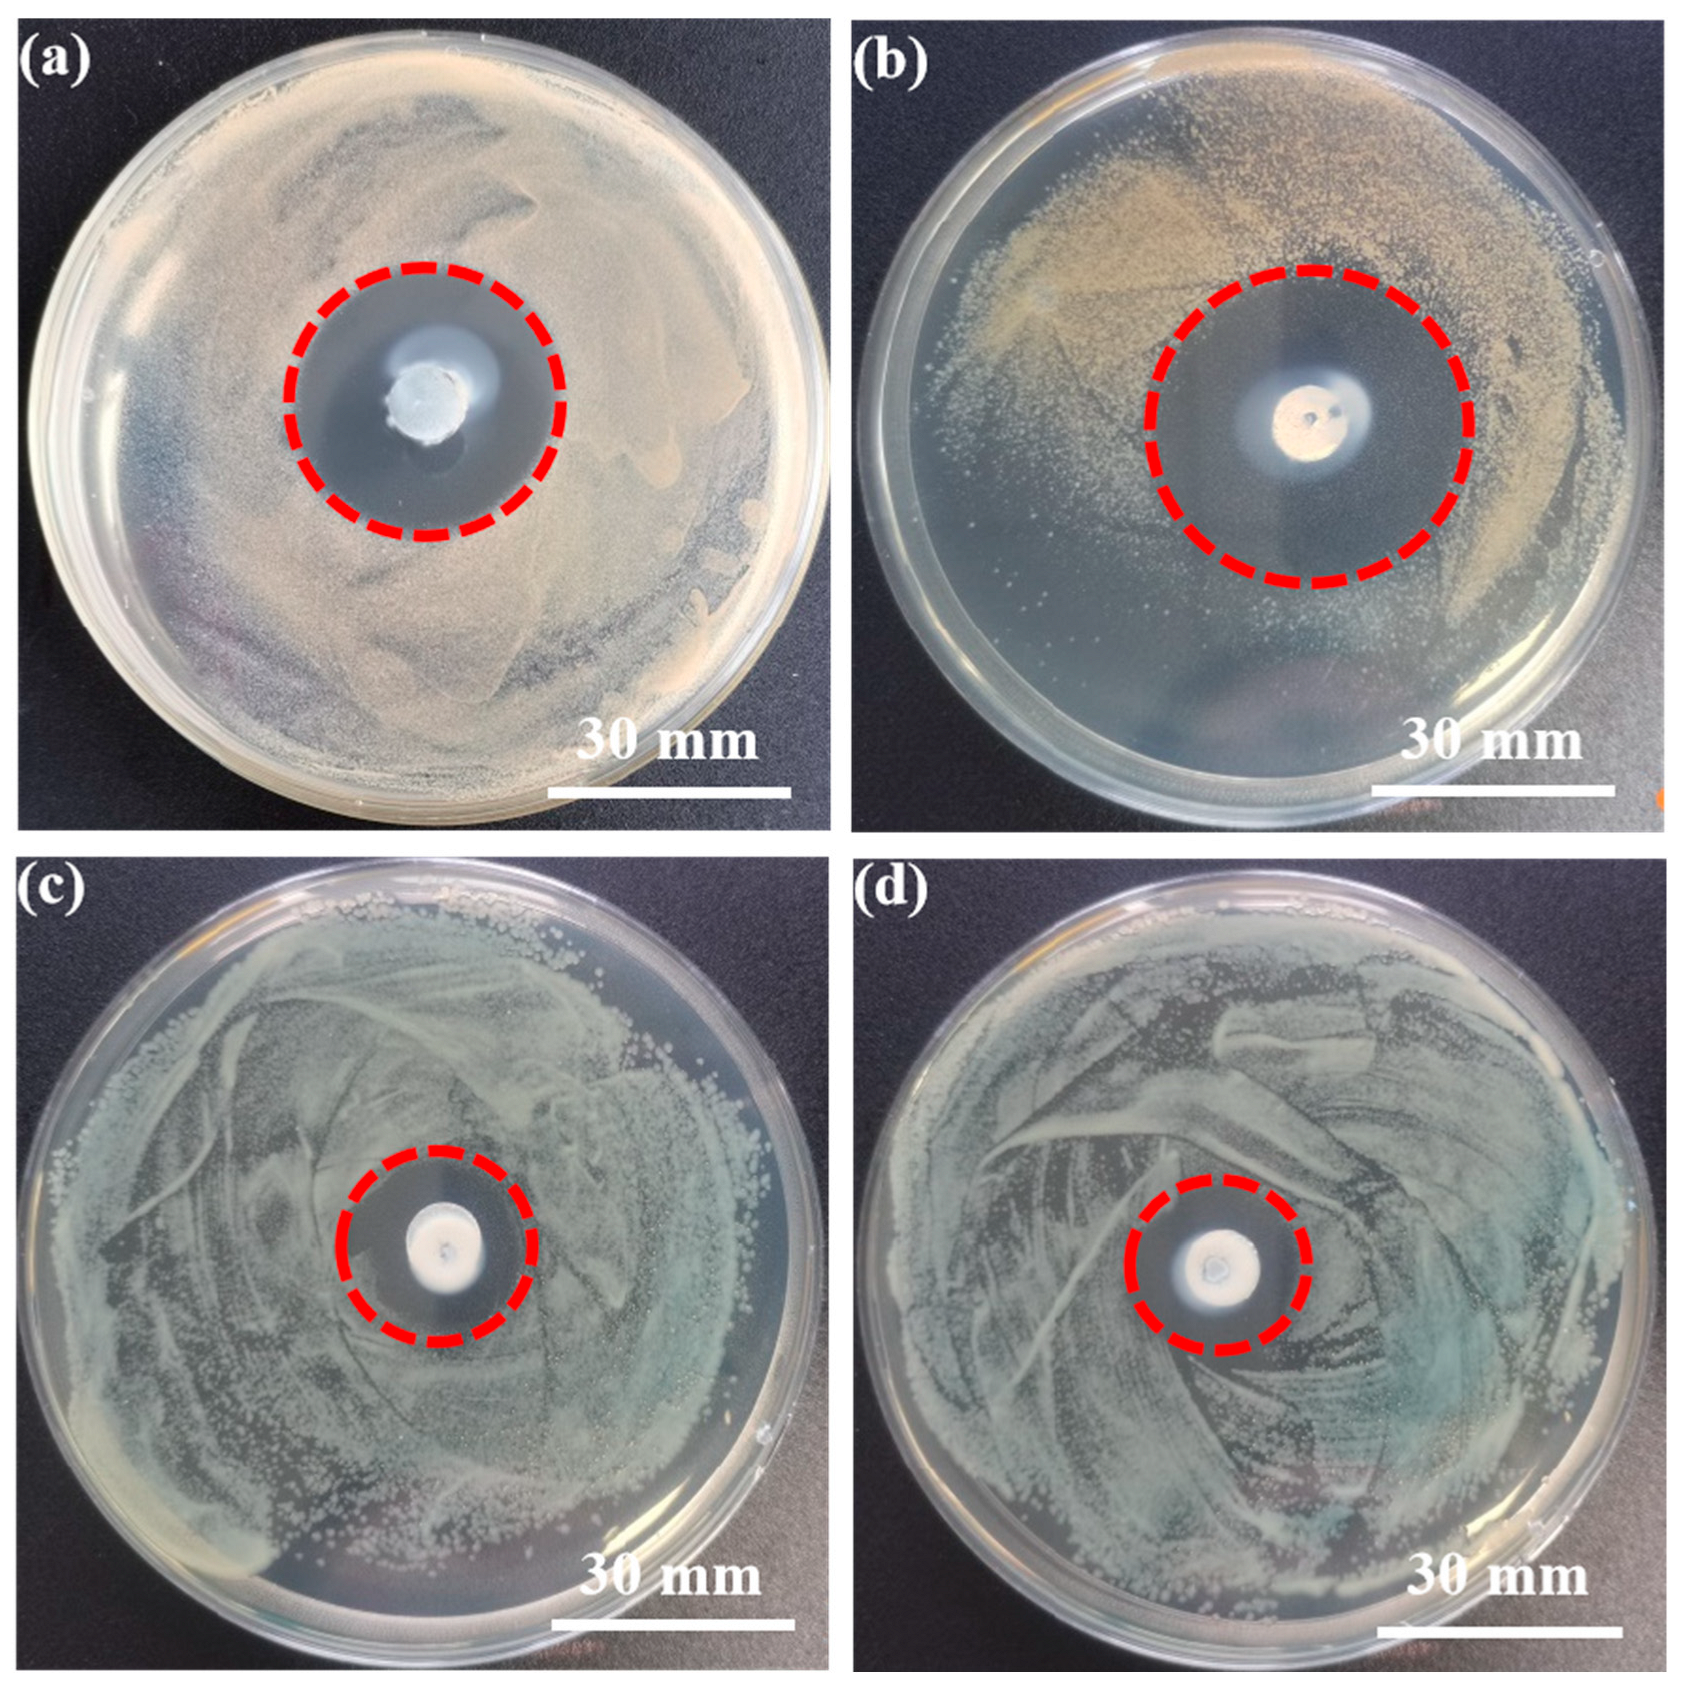
Metals 12 01444 g005 550

Microstructure, Mechanical Performance and Anti-Bacterial Activity of Degradable Zn-Cu-Ag Alloy
Abstract
:1. Introduction
2. Materials and Methods
2.1. Preparation of the Zn-1Cu-0.5Ag and Zn-1Cu-1Ag Alloys
2.2. Microstructure Observation
2.3. Mechanical Test
2.4. Degradation Behavior
2.5. Evaluation of Cytocompatibility and Anti-Bacterial Properties
2.6. Statistical Analysis
3. Results
3.1. Microstructure Observation and Phase Analysis
3.2. Mechanical Properties and Fracture Observation
3.3. Degradation Behavior of the Zn-1Cu-xAg Alloys in SBF Solution
3.4. Anti-Bacterial Performance Evaluation
3.5. Cytocompatibility Evaluation
4. Discussion
4.1. Degradation Behavior of the Zn-1Cu-xAg Alloys in SBF Solution
4.2. Antimicrobial Properties and Cytocompatibility of Zn-1Cu-xAg Alloy
5. Conclusions
- (1)
- For the Zn-1Cu-xAg (x = 0.5, 1) alloy, equiaxed microstructure with intergranular (Ag, Cu)Zn4 second phases were confirmed. The average size of the equiaxed α-Zn grains decreased from 1.91 μm to 1.64 μm with the increase in Ag content from 0.5 wt% to 1 wt%. The Zn-1Cu-1Ag alloy possessed the UTS of 292.04 MPa, the YS of 269.49 MPa, the elongation of 26.3% and the Vickers hardness value of 96.9, which can meet the mechanical requirement of biodegradable implants.
- (2)
- The primary corrosion behavior of the Zn-1Cu-xAg alloys was homogeneous corrosion, mainly because of the fine and homogeneous microstructure of the Zn-1Cu-xAg (x = 0.5, 1) alloys, which could circumvent the localized corrosion and avoid premature failure after implantation. Increased degradation rates of the Zn-1Cu-xAg alloy were to the benefit of well-matching between bone healing time and biodegradation period.
- (3)
- The results of anti-bacterial experiments show that the Zn-1Cu-xAg (x = 0.5, 1) alloy has a good anti-bacterial effect on both S. aureus and E. coli, suggesting the synergistic anti-bacterial effect of Zn, Cu and Ag. The cytotoxicity grade of the 2-fold diluted extracts of Zn-1Cu-xAg alloy is 0–1 and the cytocompatibility meets the requirements for orthopedic applications.
- (4)
- The Zn-1Cu-1Ag alloy possessed sufficient mechanical performance, moderate degradation rate, acceptable cytocompatibility and strong anti-bacterial properties, meaning that it could be a promising candidate for biomedical applications as orthopedic implants.
Author Contributions
Funding
Institutional Review Board Statement
Informed Consent Statement
Data Availability Statement
Conflicts of Interest
References
- Winder, J.; Cooke, R.S.; Gray, J.; Fannin, T.; Fegan, T. Medical rapid prototyping and 3D CT in the manufacture of custom made cranial titanium plates. J. Med. Eng. Technol. 1999, 23, 26–28. [Google Scholar] [CrossRef] [PubMed]
- Li, J.J.; Kaplan, D.L.; Zreiqat, H. Scaffold-based regeneration of skeletal tissues to meet clinical challenges. J. Mater. Chem. B 2014, 2, 7272–7306. [Google Scholar] [CrossRef] [PubMed]
- Ratheesh, G.; Venugopal, J.R.; Chinappan, A.; Ezhilarasu, H.; Sadiq, A.; Ramakrishna, S. 3D fabrication of polymeric scaffolds for regenerative therapy. ACS Biomater. Sci. Eng. 2017, 3, 1175–1194. [Google Scholar] [CrossRef] [PubMed]
- Peuster, M.A.; Wohlsein, P.E.; Brügmann, M.; Ehlerding, M.; Seidler, K.; Fink, C.H.; Brauer, H.; Fischer, A.; Hausdorf, G. A novel approach to temporary stenting: Degradable cardiovascular stents produced from corrodible metal-results 6–18 months after implantation into New Zealand white rabbits. Heart 2001, 86, 563–569. [Google Scholar] [CrossRef]
- Purnama, A.; Hermawan, H.; Couet, J.; Mantovani, D. Assessing the biocompatibility of degradable metallic materials: State-of-the-art and focus on the potential of genetic regulation. Acta Biomater. 2010, 6, 1800–1807. [Google Scholar] [CrossRef]
- Schinhammer, M.; Hänzi, A.C.; Löffler, J.F.; Uggowitzer, P.J. Design strategy for biodegradable Fe-based alloys for medical applications. Acta Biomater. 2010, 6, 1705–1713. [Google Scholar] [CrossRef]
- Kuhlmann, J.; Bartsch, I.; Willbold, E.; Schuchardt, S.; Holz, O.; Hort, N.; Höche, D.; Heineman, W.R.; Witte, F. Fast escape of hydrogen from gas cavities around corroding magnesium implants. Acta Biomater. 2013, 9, 8714–8721. [Google Scholar] [CrossRef]
- Fraga, C.G. Relevance, essentiality and toxicity of trace elements in human health. Mol. Asp. Med. 2005, 26, 235–244. [Google Scholar] [CrossRef]
- Prakasam, M.; Locs, J.; Salma-Ancane, K.; Loca, D.; Largeteau, A.; Berzina-Cimdina, L. Biodegradable materials and metallic implants—A review. J. Funct. Biomater. 2017, 8, 44. [Google Scholar] [CrossRef]
- Tang, Z.; Niu, J.; Huang, H.; Zhang, H.; Pei, J.; Ou, J.; Yuan, G. Potential biodegradable Zn-Cu binary alloys developed for cardiovascular implant applications. J. Mech. Behav. Biomed. Mater. 2017, 72, 182–191. [Google Scholar] [CrossRef]
- Tong, X.; Zhang, D.; Zhang, X.; Su, Y.; Shi, Z.; Wang, K.; Lin, J.; Li, Y.; Lin, J.; Wen, C. Microstructure, mechanical properties, biocompatibility, and in vitro corrosion and degradation behavior of a new Zn–5Ge alloy for biodegradable implant materials. Acta Biomater. 2018, 82, 197–204. [Google Scholar] [CrossRef] [PubMed]
- Arenas, M.A.; Damborenea, J.D. Protection of Zn-Ti-Cu alloy by cerium trichloride as corrosion inhibitor. Surf. Coat. Technol. 2005, 200, 2085–2091. [Google Scholar] [CrossRef]
- Sikora-Jasinska, M.; Mostaed, E.; Mostaed, A.; Beanland, R.; Mantovani, D.; Vedani, M. Fabrication, mechanical properties and in vitro degradation behavior of newly developed Zn Ag alloys for degradable implant applications. Mater. Sci. Eng. C 2017, 77, 1170–1181. [Google Scholar] [CrossRef] [PubMed]
- G 31–72; Standard Practice for Laboratory Immersion Corrosion Testing of Metals. American Society for Testing and Materials: West Conshohocken, PA, USA, 2004.
- Liu, X.; Yuan, W.; Shen, D.; Cheng, Y.; Chen, D.; Zheng, Y. Exploring the Biodegradation of Pure Zn under Simulated Inflammatory Condition. Corros. Sci. 2021, 189, 109606. [Google Scholar] [CrossRef]
- ISO 20645:2004; Textile Fabrics—Determination of The Antibacterial Activity—Agar Diffusion Plate Test. International Organization for Standardization: Geneva, Switzerland.
- ASM International. ASM Handbook: Volume. 3 Alloy Phase Diagrams; ASM International: Almere, The Netherlands, 1992. [Google Scholar]
- Liu, Z.; Qiu, D.; Wang, F.; Taylor, J.A.; Zhang, M. Crystallography of grain refinement in cast zinc–copper alloys. J. Appl. Crystallogr. 2015, 48, 890–900. [Google Scholar] [CrossRef]
- Iqbal, N.; Iqbal, S.; Iqbal, T.; Bakhsheshi-Rad, H.R.; Alsakkaf, A.; Kamil, A.; Abdul Kadir, M.R.; Idris, M.H.; Raghav, H.B. Zinc-doped hydroxyapatite—Zeolite/polycaprolactone composites coating on magnesium substrate for enhancing in-vitro corrosion and antibacterial performance. Trans. Nonferrous Met. Soc. China 2020, 30, 123–133. [Google Scholar] [CrossRef]
- Baldi, C.; Minoia, C.; Nucci, A.D.; Capodaglio, E.; Manzo, L. Effects of silver in isolated rat hepatocytes. Toxicol. Lett. 1988, 41, 261–268. [Google Scholar] [CrossRef]
- Sue, Y.M.; Lee, Y.Y.; Wang, M.C.; Lin, T.K.; Sung, J.M.; Huang, J.J. Generalized argyria in two chronic hemodialysis patients. Am. J. Kidney Dis. 2001, 37, 1048–1051. [Google Scholar] [CrossRef]
- Petrini, P.; Arciola, C.; Pezzali, I.; Bozzini, S.; Montanaro, L.; Tanzi, M.C.; Speziale, P.; Visai, L. Antibacterial activity of zinc modified titanium oxide surface. Int. J. Artif. Organs 2006, 29, 434–442. [Google Scholar] [CrossRef]
- Furchner, J.E.; Richmond, C.R.; Drake, G.A. Comparative metabolism of radionuclides in mammals-IV. Retention of silver-110m in the mouse, rat, monkey, and dog. Health Phys. 1968, 15, 355–365. [Google Scholar] [CrossRef]
- Wątroba, M.; Bednarczyk, W.; Kawałko, J.; Mech, K.; Bała, P. Design of novel Zn-Ag-Zr alloy with enhanced strength as a potential biodegradable implant material. Mater. Des. 2019, 183, 108154. [Google Scholar] [CrossRef]
- Garza-Cervantes, J.A.; Chávez-Reyes, A.; Castillo, E.C.; García-Rivas, G.; Antonio Ortega-Rivera, O.; Salinas, E.; Ortiz-Martínez, M.; Gómez-Flores, S.L.; Peña-Martínez, J.A.; Pepi-Molina, A.; et al. Synergistic antimicrobial effects of silver/transition-metal combinatorial treatments. Sci. Rep. 2017, 7, 903. [Google Scholar] [CrossRef] [PubMed]
- Qu, X.; Yang, H.; Jia, B.; Yu, Z.; Zheng, Y.; Dai, K. Biodegradable Zn–Cu alloys show antibacterial activity against MRSA bone infection by inhibiting pathogen adhesion and biofilm formation. Acta Biomater. 2020, 117, 400–417. [Google Scholar] [CrossRef] [PubMed]

| Reagents | Amount (g·L−1) |
|---|---|
| NaCl | 6.5453 |
| NaHCO3 | 2.2683 |
| KCl | 0.3728 |
| Na2HPO4. 7H2O | 0.2681 |
| MgCl2. 6H2O | 0.3050 |
| CaCl2. 2H2O | 0.3676 |
| Na2SO4 | 0.0711 |
| (CH2OH)3CNH2 | 6.0570 |
| Materials | Hardness (HV) | UTS (MPa) | YS (MPa) | δ (%) |
|---|---|---|---|---|
| Zn-1Cu-0.5Ag | 101.9 ± 3.2 | 332.90 ± 5.67 | 318.70 ± 9.20 | 26.32 ± 3.63 |
| Zn-1Cu-1Ag | 96.9 ± 2.8 | 292.04 ± 3.25 | 269.49 ± 8.71 | 35.99 ± 2.12 |
| Materials | IZD against S. aureus (mm) | IZD against E. coli (mm) |
|---|---|---|
| Zn-1Cu-0.5Ag | 11.1 ± 0.3 | 6.5 ± 0.3 |
| Zn-1Cu-1Ag | 15 ± 0.5 | 8 ± 0.2 |
Publisher’s Note: MDPI stays neutral with regard to jurisdictional claims in published maps and institutional affiliations. |
© 2022 by the authors. Licensee MDPI, Basel, Switzerland. This article is an open access article distributed under the terms and conditions of the Creative Commons Attribution (CC BY) license (https://creativecommons.org/licenses/by/4.0/).
Share and Cite
Di, T.; Xu, Y.; Liu, D.; Sun, X. Microstructure, Mechanical Performance and Anti-Bacterial Activity of Degradable Zn-Cu-Ag Alloy. Metals 2022, 12, 1444. https://doi.org/10.3390/met12091444
Di T, Xu Y, Liu D, Sun X. Microstructure, Mechanical Performance and Anti-Bacterial Activity of Degradable Zn-Cu-Ag Alloy. Metals. 2022; 12(9):1444. https://doi.org/10.3390/met12091444
Chicago/Turabian StyleDi, Tongxin, Ying Xu, Debao Liu, and Xiaohao Sun. 2022. "Microstructure, Mechanical Performance and Anti-Bacterial Activity of Degradable Zn-Cu-Ag Alloy" Metals 12, no. 9: 1444. https://doi.org/10.3390/met12091444
APA StyleDi, T., Xu, Y., Liu, D., & Sun, X. (2022). Microstructure, Mechanical Performance and Anti-Bacterial Activity of Degradable Zn-Cu-Ag Alloy. Metals, 12(9), 1444. https://doi.org/10.3390/met12091444
